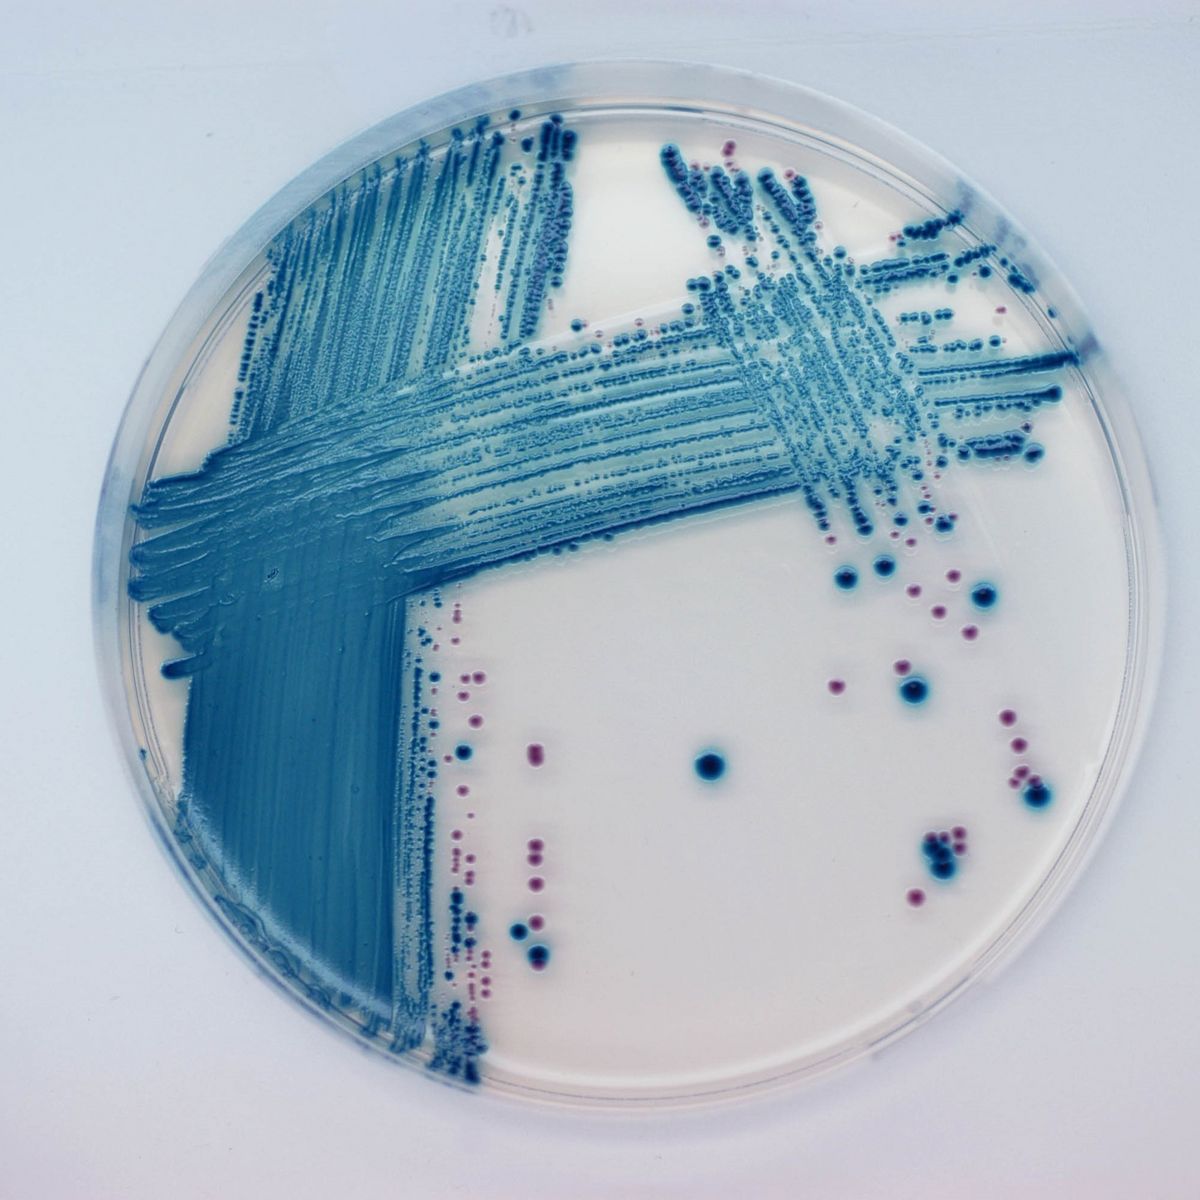
CHROMagar™ STEC - 5000 ml

EE222
For the selective isolation and differentiation of E. coli O157 in food and animal samples
Package size: 500 ml
DKK 3.000,00
DKK 3.000,00
Not in stock, delivery 1-2 weeks
Chromogenic medium for detecton of Shiga-Toxin producing E. coli (STEC).
The product is composed of a powder base (B) and 1 supplement (S).
MEDIUM PERFORMANCE:
1.Easy reading: A majority of STEC strains grow in mauve colony color, while other bacteria grow in blue, colourless or are inhibited.
2. Highly STEC selective medium: Excellent tool for large number of samples screening procedures.
3. Worldwide premiere: Unique medium in the market for STEC detection.
4. Flexibility: It can be supplemented with additional compounds to render it even more selective for the strain causing an outbreak.
TYPICAL APPEARANCE OF MICROORGANISMS:
Most common Shiga-Toxin E.coli serotypes → mauve
Other Enterobacteriacae → colourless, blue or inhibited
Gram positive bacteria → inhibited
An increasing and worrisome number of studies have lately shown that, non-O157 Shiga Toxin producing E. coli (STEC) have been responsible for foodborne poisoning outbreaks. The CDC has also reported warnings about this potental risk. Therefore, several regulatory authorites urge worldwide food industry to implement measures to control the absence of such organisms in their producton.
In many cases, laboratories have limited their search for pathogenic E. coli to the common O157 serotype. This is due, among other reasons, to the fact that were no available selectve culture media for non-O157 E. coli. CHROMagar™ STEC is designed to fll this gap.